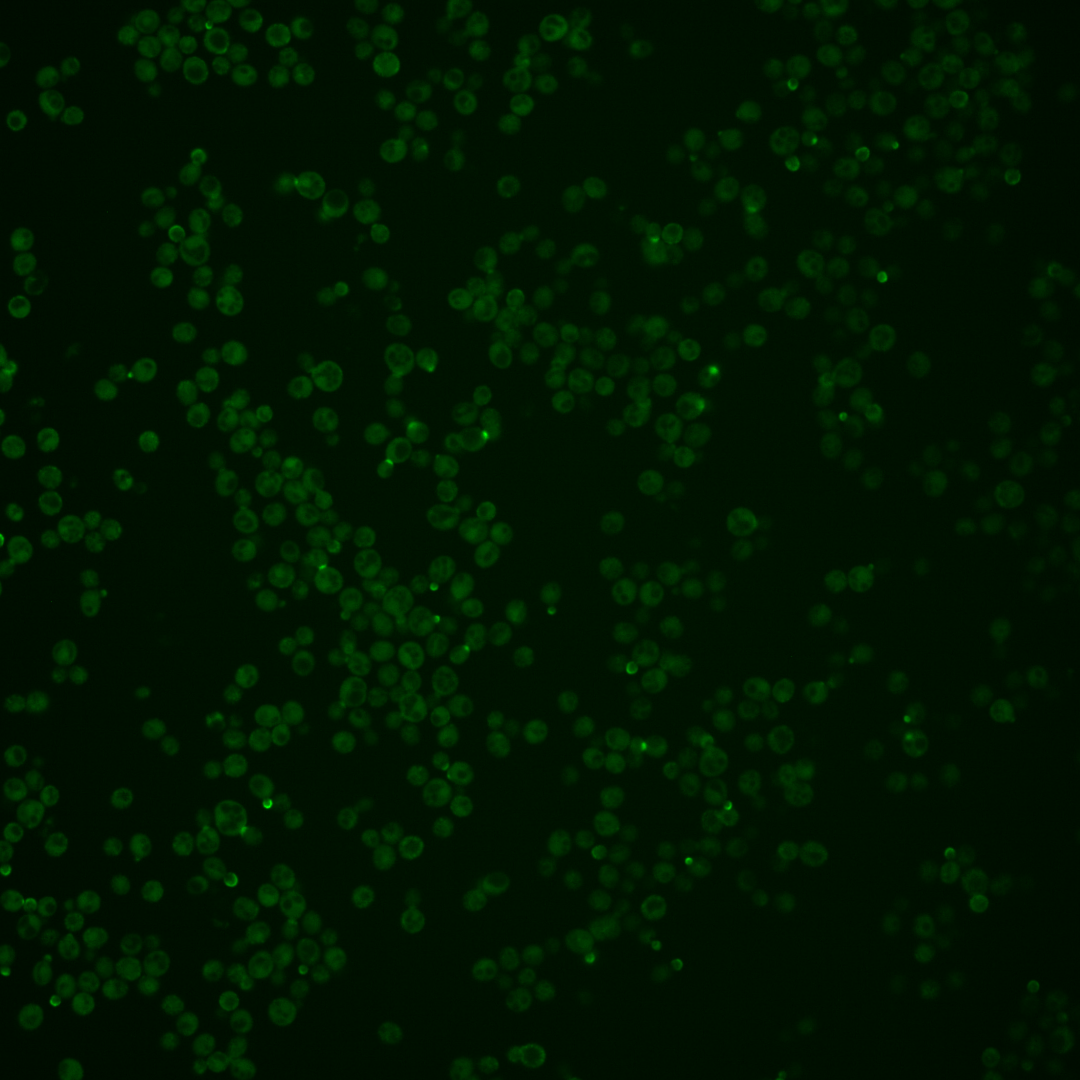
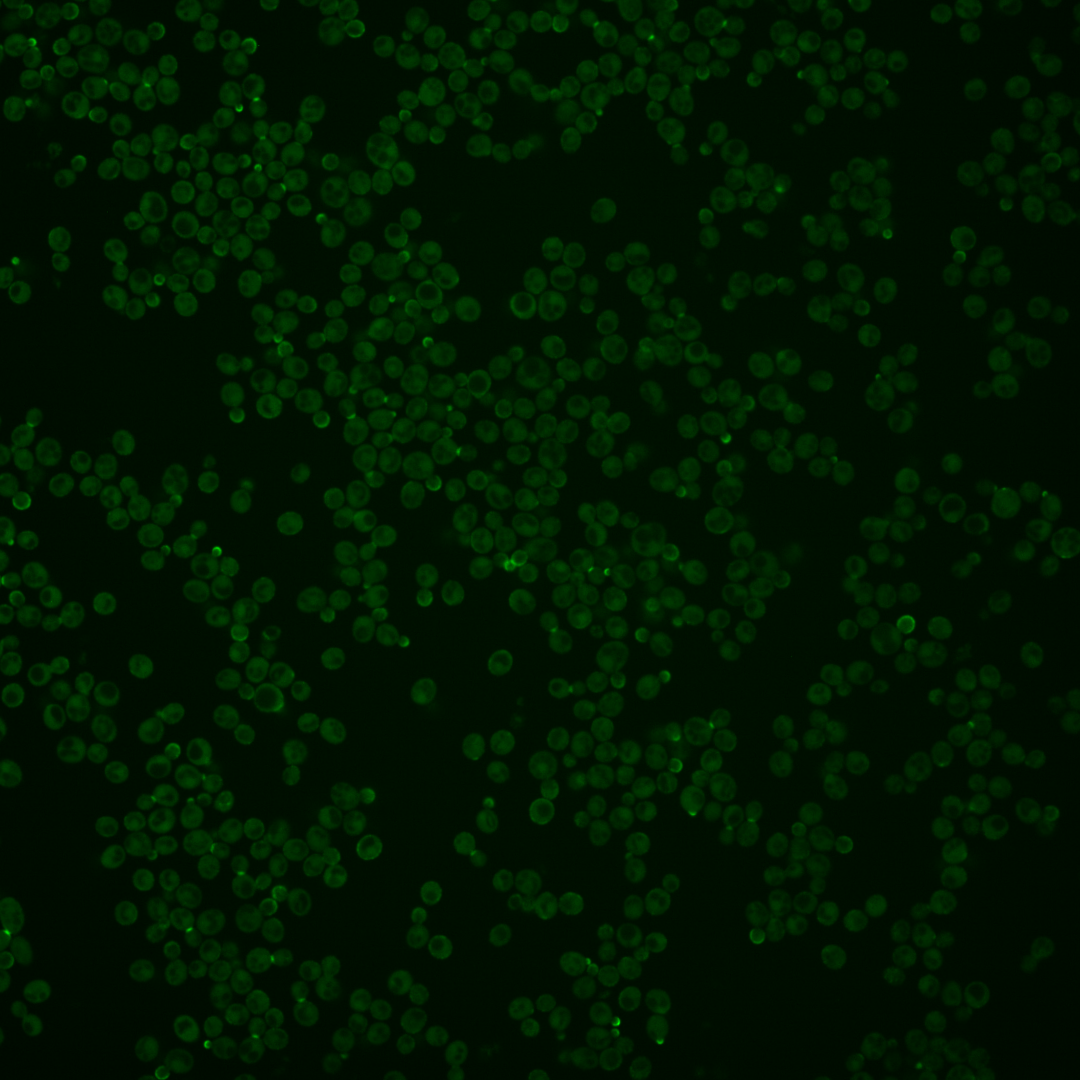
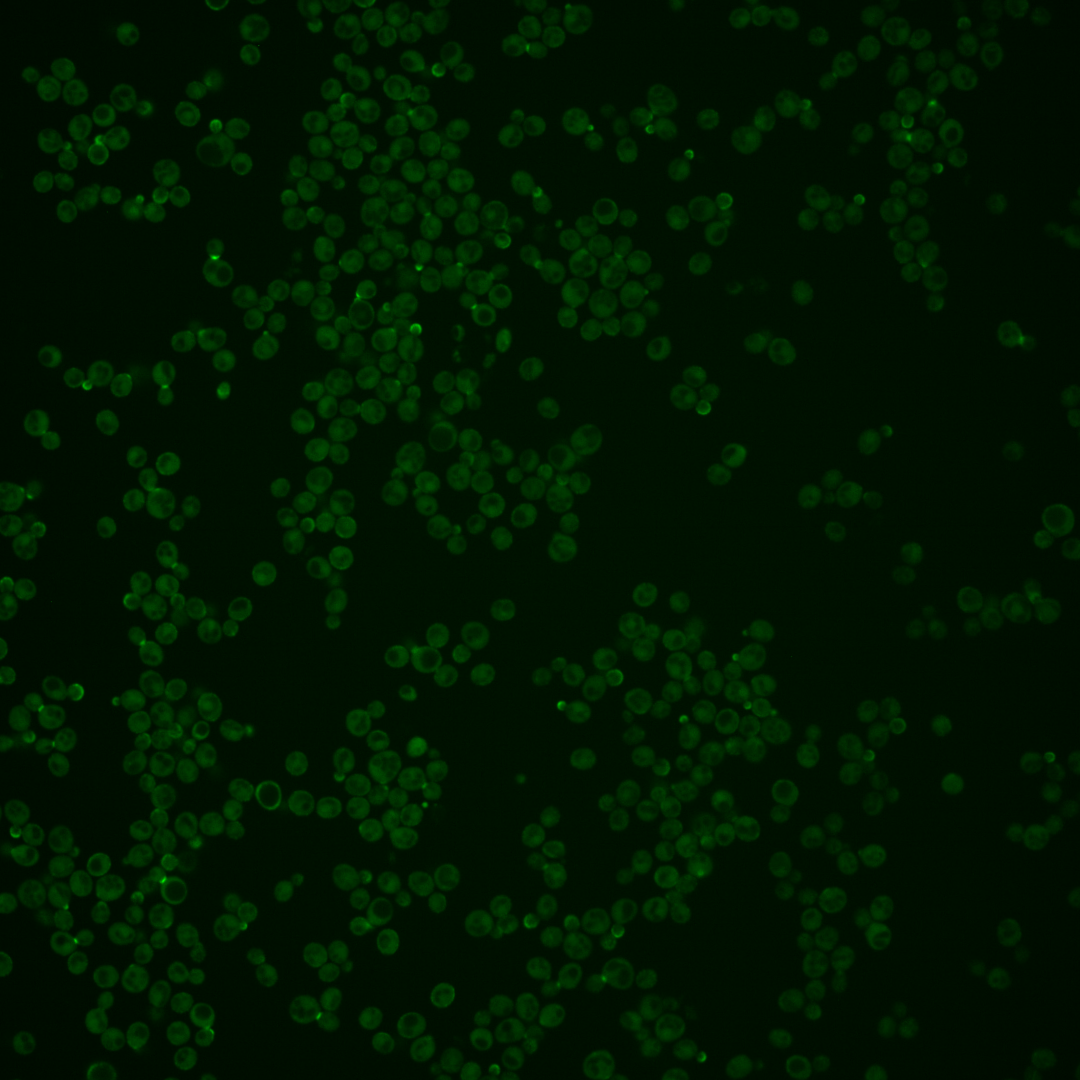

| Standard name | |
|---|---|
| Human Ortholog | |
| Description | Protein of unknown function; green fluorescent protein (GFP)-fusion protein localizes to the cell periphery, cytoplasm, bud, and bud neck; potential Cdc28p substrate; similar to Skg4p; relocalizes from bud neck to cytoplasm upon DNA replication stress; SKG3 has a paralog, CAF120, that arose from the whole genome duplication |
Micrographs




















































































Sub-cellular Localization
Yeast GFP Assignment
Protein Abundance
Localization Change
External localization resources
| ensLOC | DeepLoc | |||||||||||||||||||||||
|---|---|---|---|---|---|---|---|---|---|---|---|---|---|---|---|---|---|---|---|---|---|---|---|---|
| Localization | WT1 | WT2 | WT3 | RAP60 | RAP140 | RAP220 | RAP300 | RAP380 | RAP460 | RAP540 | RAP620 | RAP700 | HU80 | HU120 | HU160 | rpd3Δ_1 | rpd3Δ_2 | rpd3Δ_3 | WT1 | WT2 | WT3 | AF100 | AF140 | AF180 |
| Cortical Patches | 118 | 149 | 156 | 60 | 81 | 103 | 77 | 75 | 75 | – | 79 | 57 | 116 | 145 | 114 | 31 | 39 | 26 | 63 | 63 | 89 | 42 | 52 | 47 |
| Bud | 42 | 79 | 102 | 40 | 78 | 84 | 100 | 90 | 87 | – | 70 | 41 | 66 | 53 | 58 | 14 | 20 | 10 | 105 | 116 | 137 | 39 | 30 | 22 |
| Bud Neck | 1 | 3 | 13 | 1 | 5 | 3 | 9 | 10 | 5 | – | 2 | 1 | 0 | 1 | 5 | 1 | 6 | 0 | 48 | 79 | 135 | 76 | 28 | 27 |
| Bud Site | 25 | 26 | 59 | 10 | 17 | 28 | 21 | 24 | 34 | – | 6 | 18 | 6 | 3 | 1 | 5 | 3 | 0 | – | – | – | – | – | – |
| Cell Periphery | 54 | 55 | 70 | 74 | 36 | 91 | 78 | 66 | 145 | – | 104 | 84 | 186 | 364 | 384 | 14 | 36 | 47 | 54 | 41 | 66 | 5 | 10 | 26 |
| Cytoplasm | 99 | 114 | 236 | 254 | 231 | 273 | 325 | 364 | 307 | – | 185 | 160 | 270 | 463 | 534 | 25 | 49 | 65 | 28 | 35 | 89 | 288 | 362 | 460 |
| Endoplasmic Reticulum | 5 | 17 | 8 | 4 | 15 | 16 | 18 | 15 | 14 | – | 11 | 18 | 5 | 10 | 9 | 2 | 6 | 7 | 7 | 2 | 7 | 9 | 15 | 14 |
| Endosome | 1 | 1 | 4 | 2 | 8 | 6 | 1 | 8 | 2 | – | 0 | 1 | 0 | 0 | 0 | 0 | 0 | 0 | 3 | 3 | 4 | 6 | 4 | 7 |
| Golgi | 2 | 0 | 0 | 2 | 0 | 0 | 0 | 0 | 0 | – | 0 | 0 | 0 | 1 | 0 | 1 | 1 | 0 | 5 | 0 | 0 | 1 | 1 | 1 |
| Mitochondria | 3 | 9 | 20 | 23 | 21 | 110 | 156 | 255 | 263 | – | 203 | 186 | 2 | 5 | 5 | 6 | 4 | 5 | 5 | 9 | 25 | 6 | 9 | 10 |
| Nucleus | 12 | 3 | 14 | 2 | 4 | 6 | 12 | 16 | 4 | – | 3 | 5 | 3 | 3 | 2 | 2 | 5 | 4 | 0 | 0 | 0 | 0 | 0 | 0 |
| Nuclear Periphery | 0 | 0 | 0 | 0 | 0 | 1 | 2 | 3 | 4 | – | 1 | 4 | 1 | 1 | 5 | 1 | 0 | 0 | 1 | 0 | 2 | 0 | 0 | 0 |
| Nucleolus | 0 | 0 | 0 | 1 | 3 | 2 | 3 | 8 | 4 | – | 2 | 0 | 0 | 0 | 0 | 0 | 1 | 0 | 0 | 0 | 0 | 0 | 0 | 0 |
| Peroxisomes | 7 | 5 | 11 | 14 | 9 | 15 | 17 | 9 | 20 | – | 2 | 4 | 4 | 2 | 2 | 1 | 3 | 4 | 0 | 0 | 0 | 2 | 0 | 1 |
| SpindlePole | 34 | 13 | 60 | 16 | 19 | 26 | 25 | 27 | 18 | – | 1 | 3 | 13 | 9 | 8 | 8 | 7 | 6 | 1 | 0 | 7 | 0 | 1 | 2 |
| Vac/Vac Membrane | 3 | 5 | 7 | 2 | 2 | 4 | 8 | 17 | 9 | – | 3 | 4 | 2 | 1 | 0 | 4 | 10 | 3 | 2 | 12 | 15 | 7 | 3 | 8 |
| Unique Cell Count | 280 | 314 | 512 | 357 | 391 | 531 | 634 | 723 | 664 | 458 | 398 | 470 | 733 | 770 | 75 | 130 | 130 | 333 | 371 | 585 | 493 | 533 | 641 | |
| Labelled Cell Count | 406 | 479 | 760 | 505 | 529 | 768 | 852 | 987 | 991 | 672 | 586 | 674 | 1061 | 1127 | 115 | 190 | 177 | 333 | 371 | 585 | 493 | 533 | 641 | |
Yeast GFP Assignment
Protein Abundance
| Screen | WT1 | WT2 | WT3 | RAP60 | RAP140 | RAP220 | RAP300 | RAP380 | RAP460 | RAP540 | RAP620 | RAP700 | HU80 | HU120 | HU160 | rpd3Δ_1 | rpd3Δ_2 | rpd3Δ_3 | AF100 | AF140 | AF180 |
|---|---|---|---|---|---|---|---|---|---|---|---|---|---|---|---|---|---|---|---|---|---|
| Mean Cell GFP Intensity (1e-4) | 8.1 | 6.3 | 5.0 | 5.1 | 4.9 | 4.7 | 4.4 | 4.4 | 4.1 | – | 4.1 | 4.1 | 6.4 | 6.7 | 5.9 | 9.1 | 9.4 | 9.5 | 6.8 | 6.9 | 7.2 |
| Std Deviation (1e-4) | 1.5 | 1.1 | 0.8 | 1.3 | 1.1 | 1.0 | 1.0 | 1.0 | 1.0 | – | 0.8 | 0.9 | 1.1 | 1.1 | 1.0 | 1.4 | 1.9 | 1.9 | 1.3 | 1.2 | 1.1 |
| Intensity Change (Log2) | – | – | – | 0.03 | -0.02 | -0.1 | -0.18 | -0.18 | -0.29 | – | -0.28 | -0.28 | 0.36 | 0.43 | 0.24 | 0.87 | 0.91 | 0.93 | 0.44 | 0.46 | 0.53 |
Localization Change
| Localization | RAP60 | RAP140 | RAP220 | RAP300 | RAP380 | RAP460 | RAP540 | RAP620 | RAP700 | HU80 | HU120 | HU160 | rpd3Δ_1 | rpd3Δ_2 | rpd3Δ_3 |
|---|---|---|---|---|---|---|---|---|---|---|---|---|---|---|---|
| Cortical Patches | -4.6 | -3.3 | 0 | 0 | 0 | 0 | – | 0 | 0 | -2.0 | -4.3 | -6.7 | 1.9 | -0.1 | -2.4 |
| Bud | -3.4 | 0 | 0 | 0 | 0 | 0 | – | 0 | 0 | -2.4 | -6.7 | -6.6 | -0.3 | -1.2 | -3.3 |
| Bud Neck | -2.6 | -1.3 | 0 | 0 | 0 | 0 | – | 0 | 0 | -3.5 | -4.0 | -2.8 | 0 | 0 | 0 |
| Bud Site | -4.7 | -3.8 | 0 | 0 | 0 | 0 | – | 0 | 0 | -6.5 | -8.9 | -9.5 | -1.3 | -3.2 | -4.1 |
| Cell Periphery | 2.8 | -2.1 | 0 | 0 | 0 | 0 | – | 0 | 0 | 9.2 | 13.1 | 13.3 | 1.2 | 3.8 | 5.9 |
| Cytoplasm | 7.3 | 3.9 | 1.7 | 1.7 | 1.5 | 0 | – | -1.8 | -1.8 | 3.6 | 6.0 | 8.3 | -2.1 | -1.7 | 0.8 |
| Endoplasmic Reticulum | 0 | 2.1 | 0 | 0 | 0 | 0 | – | 0 | 0 | -0.7 | -0.3 | -0.6 | 0 | 0 | 0 |
| Endosome | 0 | 1.6 | 0 | 0 | 0 | 0 | – | 0 | 0 | 0 | 0 | 0 | 0 | 0 | 0 |
| Golgi | 0 | 0 | 0 | 0 | 0 | 0 | – | 0 | 0 | 0 | 0 | 0 | 0 | 0 | 0 |
| Mitochondria | 1.7 | 1.0 | 0 | 0 | 0 | 0 | – | 0 | 0 | -3.7 | -4.0 | -4.1 | 0 | 0 | 0 |
| Nucleus | -2.3 | -1.8 | -1.9 | -1.0 | -0.6 | -3.0 | – | -2.5 | -1.5 | -2.5 | -3.5 | -3.9 | 0 | 0 | 0 |
| Nuclear Periphery | 0 | 0 | 0 | 0 | 0 | 0 | – | 0 | 0 | 0 | 0 | 0 | 0 | 0 | 0 |
| Nucleolus | 0 | 0 | 0 | 0 | 0 | 0 | – | 0 | 0 | 0 | 0 | 0 | 0 | 0 | 0 |
| Peroxisomes | 1.5 | 0.2 | 0 | 0 | 0 | 0 | – | 0 | 0 | -1.7 | -3.2 | -3.3 | 0 | 0 | 0 |
| SpindlePole | -3.7 | -3.6 | 0 | 0 | 0 | 0 | – | 0 | 0 | -5.3 | -8.0 | -8.4 | -0.3 | -2.1 | -2.4 |
| Vacuole | 0 | 0 | -1.0 | -0.2 | 1.2 | 0 | – | 0 | 0 | 0 | 0 | 0 | 0 | 0 | 0 |
External localization resources
Images






























Protein Concentration and Protein Localization Data
| R1 | R2 | R3 | ||||||||||||||||
|---|---|---|---|---|---|---|---|---|---|---|---|---|---|---|---|---|---|---|
| G1 Pre-START | G1 Post-START | S/G2 | Metaphase | Anaphase | Telophase | G1 Pre-START | G1 Post-START | S/G2 | Metaphase | Anaphase | Telophase | G1 Pre-START | G1 Post-START | S/G2 | Metaphase | Anaphase | Telophase | |
| Concentration | 3.4502 | 3.2194 | 3.2936 | 3.3701 | 2.9847 | 3.9385 | 0.8795 | 0.9591 | 1.1711 | 1.1737 | 0.9931 | 1.4997 | 6.2734 | 6.3689 | 6.7607 | 7.3269 | 6.5929 | 6.8005 |
| Actin | 0.0757 | 0.0171 | 0.0335 | 0.1152 | 0.0347 | 0.0277 | 0.0264 | 0.018 | 0.0078 | 0.0134 | 0.04 | 0.0173 | 0.019 | 0.0114 | 0.0131 | 0.0099 | 0.0337 | 0.0363 |
| Bud | 0.0484 | 0.0537 | 0.3106 | 0.0846 | 0.066 | 0.0194 | 0.0704 | 0.0808 | 0.3416 | 0.0887 | 0.0855 | 0.0267 | 0.0467 | 0.0889 | 0.2727 | 0.1052 | 0.1165 | 0.0267 |
| Bud Neck | 0.0467 | 0.0124 | 0.0264 | 0.0191 | 0.1023 | 0.5705 | 0.0289 | 0.0051 | 0.001 | 0.0041 | 0.0037 | 0.4892 | 0.0476 | 0.0074 | 0.0062 | 0.0106 | 0.04 | 0.4441 |
| Bud Periphery | 0.1656 | 0.0737 | 0.4882 | 0.5485 | 0.5585 | 0.0817 | 0.2116 | 0.1389 | 0.5071 | 0.6145 | 0.7243 | 0.1587 | 0.1878 | 0.147 | 0.519 | 0.73 | 0.6598 | 0.122 |
| Bud Site | 0.2333 | 0.3593 | 0.0618 | 0.0413 | 0.01 | 0.0145 | 0.1846 | 0.3733 | 0.073 | 0.0216 | 0.0047 | 0.0287 | 0.2737 | 0.3674 | 0.0899 | 0.0153 | 0.0299 | 0.0266 |
| Cell Periphery | 0.124 | 0.0746 | 0.0155 | 0.0327 | 0.0421 | 0.0544 | 0.13 | 0.0324 | 0.0106 | 0.038 | 0.0505 | 0.0287 | 0.2046 | 0.05 | 0.0287 | 0.0298 | 0.0433 | 0.0663 |
| Cytoplasm | 0.1416 | 0.2688 | 0.0262 | 0.03 | 0.0213 | 0.1776 | 0.2727 | 0.2464 | 0.0307 | 0.1247 | 0.0591 | 0.1896 | 0.1706 | 0.2464 | 0.046 | 0.0403 | 0.0694 | 0.2261 |
| Cytoplasmic Foci | 0.0103 | 0.0025 | 0.0026 | 0.0095 | 0.0472 | 0.0058 | 0.0084 | 0.0077 | 0.001 | 0.0028 | 0.0011 | 0.0111 | 0.0079 | 0.0037 | 0.001 | 0.0045 | 0.0006 | 0.0086 |
| Eisosomes | 0.0033 | 0.0011 | 0.0003 | 0.0019 | 0.0011 | 0.0002 | 0.0026 | 0.0021 | 0.0001 | 0.0005 | 0.0034 | 0.0007 | 0.0015 | 0.0007 | 0.0003 | 0.0002 | 0.0002 | 0.0005 |
| Endoplasmic Reticulum | 0.004 | 0.0029 | 0.0011 | 0.0029 | 0.0033 | 0.009 | 0.0064 | 0.0044 | 0.001 | 0.0131 | 0.0055 | 0.0034 | 0.0038 | 0.0036 | 0.0009 | 0.0009 | 0.0009 | 0.002 |
| Endosome | 0.0151 | 0.0018 | 0.0033 | 0.0061 | 0.0062 | 0.0099 | 0.0027 | 0.0044 | 0.0006 | 0.0026 | 0.0007 | 0.0041 | 0.0031 | 0.0014 | 0.0004 | 0.0022 | 0.0003 | 0.0012 |
| Golgi | 0.0081 | 0.0006 | 0.0017 | 0.0114 | 0.0093 | 0.0056 | 0.0015 | 0.0013 | 0.0002 | 0.0007 | 0.0006 | 0.0022 | 0.0013 | 0.0007 | 0.0003 | 0.0005 | 0.0002 | 0.0011 |
| Lipid Particles | 0.0118 | 0.0008 | 0.0014 | 0.018 | 0.0098 | 0.004 | 0.0017 | 0.0008 | 0.0001 | 0.0005 | 0.0002 | 0.0012 | 0.0015 | 0.0004 | 0.0001 | 0.0002 | 0 | 0.0006 |
| Mitochondria | 0.0097 | 0.0004 | 0.0019 | 0.0124 | 0.0072 | 0.0019 | 0.0013 | 0.002 | 0.001 | 0.0023 | 0.0018 | 0.0038 | 0.0012 | 0.0009 | 0.0025 | 0.0018 | 0.001 | 0.0008 |
| None | 0.0533 | 0.114 | 0.012 | 0.0083 | 0.0671 | 0.0018 | 0.0333 | 0.0669 | 0.0136 | 0.0434 | 0.0107 | 0.0193 | 0.0138 | 0.0605 | 0.0144 | 0.0355 | 0.0014 | 0.0257 |
| Nuclear Periphery | 0.0045 | 0.0004 | 0.0025 | 0.005 | 0.0024 | 0.0074 | 0.0008 | 0.0009 | 0.0005 | 0.0026 | 0.0017 | 0.0006 | 0.0012 | 0.0008 | 0.0002 | 0.0006 | 0.0002 | 0.0003 |
| Nucleolus | 0.0016 | 0.0006 | 0.0006 | 0.0007 | 0.0005 | 0.0004 | 0.0008 | 0.0011 | 0.0005 | 0.0015 | 0.0002 | 0.0016 | 0.0008 | 0.0007 | 0.0005 | 0.0008 | 0.0002 | 0.0008 |
| Nucleus | 0.0144 | 0.0016 | 0.0014 | 0.0009 | 0.0012 | 0.0013 | 0.0018 | 0.0041 | 0.0016 | 0.006 | 0.0019 | 0.0024 | 0.002 | 0.0041 | 0.0009 | 0.0021 | 0.0007 | 0.0014 |
| Peroxisomes | 0.0094 | 0.0002 | 0.0012 | 0.0482 | 0.0023 | 0.0012 | 0.0006 | 0.0008 | 0.0002 | 0.0004 | 0.0002 | 0.0011 | 0.001 | 0.0002 | 0.0002 | 0.0004 | 0.0002 | 0.0017 |
| Punctate Nuclear | 0.0039 | 0.0004 | 0.0025 | 0.0013 | 0.0021 | 0.0014 | 0.0005 | 0.0012 | 0.0002 | 0.0009 | 0.0003 | 0.001 | 0.0015 | 0.0005 | 0.0001 | 0.0018 | 0.0001 | 0.0014 |
| Vacuole | 0.0139 | 0.0126 | 0.0049 | 0.0013 | 0.0043 | 0.0034 | 0.0125 | 0.0071 | 0.0067 | 0.0161 | 0.0036 | 0.008 | 0.009 | 0.003 | 0.0024 | 0.0067 | 0.0012 | 0.0054 |
| Vacuole Periphery | 0.0013 | 0.0004 | 0.0003 | 0.0008 | 0.0009 | 0.0007 | 0.0006 | 0.0004 | 0.0009 | 0.0016 | 0.0005 | 0.0007 | 0.0004 | 0.0002 | 0.0002 | 0.0006 | 0.0001 | 0.0003 |
Sequencing Data
| R1 | R2 | |||||||||
|---|---|---|---|---|---|---|---|---|---|---|
| G1 Post-START | S/G2 | Metaphase | Anaphase | Telophase | G1 Post-START | S/G2 | Metaphase | Anaphase | Telophase | |
| Gene Expression | 18.2647 | 19.2089 | 12.1157 | 14.9131 | 13.4657 | 11.0959 | 20.3932 | 20.646 | 15.909 | 18.4689 |
| Translational Efficiency | 1.1128 | 1.117 | 1.3601 | 0.8415 | 0.9256 | 1.7836 | 0.9999 | 0.8187 | 1.0138 | 0.9127 |
Hit Data
| Dataset | Hit |
|---|---|
| Protein Concentration | ✔ |
| Protein Localization | ✔ |
| Gene Expression | ✘ |
| Translational Efficiency | ✘ |
Endocytosis
| Temp | Actin Patch (Sac6-tdTomato) | Cortical Patch (Sla1-GFP) | Late Endosome (Snf7-GFP) | Vacuole (Vph1-GFP) |
|---|---|---|---|---|
| 37℃ | ||||
| RT |
Cell Cycle Omics
CYCLoPs (Skg3-GFP)
| Gene / Allele | Actin Patch (Sac6-tdTomato) | Cortical Patch (Sla1-GFP) | Late Endosome (Snf7-GFP) | Vacuole (Sac6-tdTomato) |
|---|
| Gene | Images |
|---|
| Gene | Images |
|---|
Images are not yet available
Images are not yet available